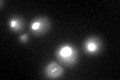
YGR271C-A

View description
Essential protein required for maturation of 18S rRNA; null mutant is sensitive to hydroxyurea and is delayed in recovering from alpha-factor arrest; green fluorescent protein (GFP)-fusion protein localizes to the nucleolus
Localization:
Intensity:
Fold change:
Significance:
-
C’ GFP library in SD

nucleolus50.62 -
N' NOP1pr-GFP in SD

nucleolus109.549 -
N' TEF2pr-mCherry in SD

nucleus,nucleolus148.605 -
N' NATIVEpr-GFP in SD

nucleus,nucleolus57.2354 -
N' TEF2pr-VC and Cyto-VN in SD

#N/A0 -
C’ GFP library in SD+DTT
nucleolus39.270.77No -
C’ GFP library in SD+H2O2

nucleolus53.711.06No -
C’ GFP library in Starvation Media

nucleolus29.190.57Yes -
C’ GFP library on the background of Pup2-DaMP

nucleolus -
C’ GFP library on the background of CCT mutant

nucleolus44.66150.882123No
